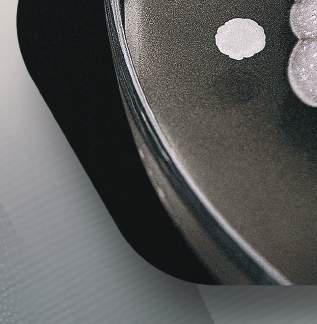

![]()









A Koppert é a maior produtora e comercializadora de insumos biológicos agrícolas do Brasil e do mundo. Sua experiência e sua história em levar um manejo mais sustentável e saudável aos agricultores são fundamentais para uma produção de alimentos mais segura, equilibrada e de acordo com as boas práticas agrícolas.
Há mais de 55 anos, trabalhamos em parceria com pesquisadores e especialistas para que a agricultura seja cada vez mais sustentável, garantindo um futuro com saúde e produtividade.















Primeiros produtos registrados no Brasil;


Lançamento do Gazebo, primeiro hub de inovação voltado a biodefensivos do Brasil;
Aquisição da empresa Itaforte Bioprodutos;
Lançamento do SparcBio (São Paulo Advanced Research Center for Biological Control), Centro Avançado de Pesquisas em Controle Biológico);

Aquisição da Geocom, empresa de geoprocessamento de imagens e aplicação de agentes biológicos;

Inauguração da Unidade de Formulações, em Charqueada (SP);


Aquisição da Manejo Agrícola, maior distribuidora de defensivos biológicos do mercado brasileiro;

Espigão Ltda.


Aquisição da Espigão Ltda., empresa de distribuição de MS;
Aquisição da Nitrasoil, empresa argentina, de inoculantes;
Aquisição da Bug Agentes Biológicos, especializada em agentes de controle macrobiológico;


Inauguração do escritório administrativo Koppert na cidade de Ribeirão Preto (SP);
Criação da Koppert América do Sul com a incorporação dos países andinos à administração brasileira.



A Koppert conta com departamento próprio de P&D para aperfeiçoamento de tecnologias de controle biológico. Sua equipe é composta por pesquisadores e especialistas que trabalham em parceria com renomadas universidades e institutos de pesquisa para sempre inovar e evoluir na busca pelos melhores bioinsumos.







A companhia possui, no Brasil, uma infraestrutura completa, moderna e automatizada para atender à crescente demanda do mercado agrícola nacional e sulamericano por bioinsumos. Investe constantemente na expansão de sua capacidade fabril e na excelência de seus processos produtivos - padronizados, seguros e altamente tecnificados -, que garantem confiabilidade e qualidade ao seu portfólio.



Logística


Os insumos biológicos são feitos a partir de organismos vivos, que necessitam de condições especiais de armazenamento e transporte. Para tanto, a Koppert faz o controle e a verificação de temperatura e formas de transporte e armazenamento durante todo o processo logístico, de forma a garantir a qualidade final de seus produtos.










Unidade Koppert
Equador
Unidade Koppert Peru




Como estratégia de expansão de negócios, a Koppert Brasil passou, em 2024, a gerir as unidades da companhia no Chile, Colômbia, Equador e Peru. Com isso, a subsidiária brasileira, que já era responsável por Argentina, Uruguai e Paraguai, passa a operar a Koppert América do Sul.


Unidade Koppert Colômbia



Unidade Koppert Chile
Unidade Koppert
Argentina


Buenos Aires
• Inoculantes
Acesse o Mapa de Revendedores Koppert Brasil




Unidades Koppert Brasil
Charqueada (SP)
• Macrobiológicos
• Formulações
• Logística
Unidades Koppert Brasil
Piracicaba (SP)
• Microbiológicos
• Natutec®

Escritório Koppert Brasil
Ribeirão Preto (SP)
Unidade Koppert
Uruguai
Matriz Somax
• Distribuidor Exclusivo
Koppert
Hernandarias, Alto Paraná (Paraguai)



Lançado em 2020, o SPARCBio (São Paulo Advanced Research Center for Biological Control) é o primeiro centro avançado de pesquisas especializado em controle biológico do país. Fruto da parceria e investimentos da Koppert, da Escola Superior de Agricultura “Luiz de Queiroz” (Esalq/USP) e da FAPESP (Fundação de Amparo à Pesquisa do Estado de São Paulo), tem como foco o desenvolvimento de tecnologias biológicas para o manejo de pragas e doenças na agricultura brasileira.



sparcbio.com.br


O Gazebo é o hub de inovação da Koppert Brasil, o primeiro especializado em tecnologias voltadas para o controle biológico. Como parte integrante da estratégia de evolução da empresa, o hub agrega startups, empresas e instituições de pesquisa que desenvolvem soluções aplicadas ao manejo integrado de pragas e doenças em agricultura tropical, com foco em inovação e sustentabilidade.





O aplicativo de compatibilidade de produtos Koppert demonstra de forma rápida e prática a interação entre os bioinsumos e os agroquímicos e fertilizantes.

Mostra ao usuário quais produtos podem ser aplicados de forma conjunta ou sequencial, e os que não devem interagir.
Um importante diferencial é que o App funciona off-line, facilitando a pesquisa em lugares sem acesso à internet.




A Koppert oferece um vasto e especializado portfólio de produtos microbiológicos para controle de pragas e doenças, como fungicidas, nematicidas e inseticidas. Formulados à base de fungos, vírus e bactérias, combatem as principais pragas e doenças com agentes naturais e controle.














Trichoderma harzianum 1306
TRICHODERMIL é um biofungicida e bionematicida que proporciona melhor desenvolvimento radicular da planta. Com dupla proteção, controla o ataque de fungos e nematoides de solo.











CEPA: ESALQ 1306 (Exclusiva Koppert)

Indicação: Todas as culturas

Registro no MAPA: 2007








Queima-da-saia, Rizoctoniose, Tombamento, Podridão-radicular (Rhizoctonia solani), Podridão-radicular-seca (Fusarium solani f.sp. phaseoli), Mofo-branco, Podridão-da-hasteda-soja (Sclerotina sclerotiorum), Nematoide-das-lesões (Pratylenchus zeae).

Modo de ação Trichodermil





















Micoparasitismo: 1
Trichoderma é capaz de parasitar fungos fitopatogênicos.
Benefícios do produto

Redução do inóculo de doenças de solo (fungos e nematoides).



2
Competição:








Trichoderma coloniza o sistema radicular da planta competindo com fitopatógenos por espaço e alimento.

3
Antibiose:
Trichoderma secreta diversos metabólitos secundários que são capazes de inibir e proteger as raízes contra a ação de fungos e nematoides fitopatogênicos.

Maior atividade na rizosfera da planta.

Maior sanidade e desenvolvimento radicular.
*Informações sobre dosagem e modo de aplicação, consultar a bula do produto disponível no QRCode ao lado.











Beauveria bassiana PL63
BOVERIL EVO é um bioinseticida com eficiência agronômica comprovada no controle de Percevejo-marrom (Euschistus heros), Mosca-branca (Bemisia tabaci) e Ácaro-rajado (Tetranychus urticae).











CEPA: ESALQ PL63 (Exclusiva Koppert)

Indicação: Todas as culturas

Registro no MAPA: 17520







Mosca-branca (Bemisia tabaci), Percevejo-marrom (Euschistus heros) e Ácaro-rajado (Tetranychus urticae).




Os esporos se dispersam e atingem o tegumento do inseto.





Os esporos germinam e penetram no corpo do inseto.




Benefícios do produto

O fungo coloniza todo o interior do inseto e libera toxinas que levam o inseto a morte.


















Mais viabilidade (tempo de prateleira) e vigor aos esporos de Beauveria Maior período de armazenamento. Amplo espectro


4 O fungo se multiplica no inseto. Os insetos infectados podem contaminar insetos sadios. Saiba mais












Bacillus pumilus Mancha-parda (Septoria glycines), Mancha-alvo (Corynespora cassiicola) e Crestamento-foliar-de-cercospora (Cercospora kikuchii), Falso oídio; Ramularia (Ramularia areola), Mancha-de-Phaeosphaeria; Mancha-foliar (Phaeosphaeria maydis) e Antracnose (Colletotrichum lindemuthianum).
CARAVAN é um biofungicida multiação contra patógenos, que promove ampla proteção contra doenças foliares.

CEPA: CNPSo 3203

Indicação: Todas as culturas

Registro no MAPA: 4721






Mancha-parda (Septoria glycines), Mancha-alvo (Corynespora cassiicola) e Crestamento-foliar-de-cercospora (Cercospora kikuchii), Falso oídio; Ramularia (Ramularia areola), Mancha-de-Phaeosphaeria; Mancha-foliar (Phaeosphaeria maydis) e Antracnose (Colletotrichum lindemuthianum).



Caravan é aplicado através de pulverizações foliares.











A bactéria forma um biofilme sobre a folha e produz metabólitos que agem diretamente no desenvolvimento de patógenos, inibindo a germinação dos esporos. Além disso, alguns metabólitos promovem a indução de resistência das plantas contra a ação dos fungos fitopatogênicos.

















Maior sanidade foliar. Contribui para manejo de resistência das doenças.




















Compatibilidade com outros métodos de controle.
*Informações sobre dosagem e modo de aplicação, consultar a bula do produto disponível no QRCode ao lado.


















Metarhizium anisopliae E9
METARRIL é um bioinseticida com eficiência agronômica comprovada no controle da Cigarrinha-da-raiz (Mahanarva fimbriolata).











CEPA: ESALQ E9 (Exclusiva Koppert)

Indicação: Todas as culturas

Registro no MAPA: 6605





Cigarrinha-da-raiz (Mahanarva fimbriolata).




Modo de ação Metarril

Os esporos germinam e penetram no corpo do inseto.


Os esporos se dispersam e atingem o tegumento do inseto.









Ideal para Manejo Integrado de Pragas (MIP).


O fungo coloniza todo o interior do inseto e libera toxinas que levam o inseto a morte.




Indicado para manejo de resistência de insetos-praga a inseticidas químicos.

Preserva os inimigos naturais das pragas.


O fungo se multiplica no inseto. Os insetos infectados podem contaminar insetos sadios.










Isaria fumosorosea 1296
OCTANE é um bioinseticida com eficiência agronômica comprovada no controle de Cigarrinha-do-milho (Dalbulus maidis), Helicoverpa armigera, Ácaro-rajado (Tetranychus urticae) e Tripes (Frankliniella schultzei).











CEPA: ESALQ 1296 (Exclusiva Koppert)

Indicação: Todas as culturas

Registro no MAPA: 30917




Alvos


Cigarrinha-do-milho (Dalbulus maidis), Helicoverpa armigera, Ácaro-rajado (Tetranychus urticae) e Tripes (Frankliniella schultzei).

Modo de ação Octane





Os esporos se dispersam e atingem o tegumento do inseto.

Os esporos germinam e penetram no corpo do inseto.





Benefícios do produto

O fungo coloniza todo o interior do inseto e libera toxinas que levam o inseto a morte.




O fungo se multiplica no inseto. Os insetos infectados podem contaminar insetos sadios.

A CEPA 1296 foi avaliada em trabalhos científicos, apresentando maior resistência aos raios UVB em comparação às outras cepas de Isaria fumosorosea (Cordyceps javanica).
Ideal para Manejo Integrado de Pragas (MIP).
Indicado para manejo de resistência de insetos-praga a inseticidas químicos.


Preserva os inimigos naturais das pragas.
*Informações sobre dosagem e modo de aplicação, consultar a bula do produto disponível no QRCode ao lado.









Vírus SfMNPV
BUICK é um bioinseticida com eficiência agronômica comprovada no controle da Lagarta-do-cartucho (Spodoptera frugiperda).











Linhagem: Vírus SfMNPV

Indicação: Todas as culturas

Registro no MAPA: 19920




Alvo



Lagarta-do-cartucho (Spodoptera frugiperda).

Modo de ação Buick





As partículas virais são pulverizadas e recobrem a planta.
A lagarta se alimenta da planta e ingere as partículas virais.













Benefícios do produto


Após a morte a lagarta se liquefaz, espalhando um líquido contendo o vírus na superfície da planta.

Indicado para manejo de resistência de insetos-praga a inseticidas químicos.
Não possui período de carência. Ideal para Manejo Integrado de Pragas (MIP).






A lagarta infectada para de se alimentar e sua coloração evolui para esbranquiçado. *Informações sobre dosagem e modo de aplicação, consultar a bula do produto disponível no QRCode ao lado.



A lagarta morta espalha partículas do vírus que irão infectar outras lagartas.

















MONTEREY é um feromônio semioquímico recomendado no controle da Lagarta-do-cartucho (Spodoptera frugiperda). Após sua liberação, o produto age por confusão sexual, interferindo na capacidade dos insetos machos localizarem as fêmeas, evitando o acasalamento.



Classe: Feromônio semioquímico

Indicação: Todas as culturas

Registro no MAPA: 16520




Alvo




Lagarta-do-cartucho (Spodoptera frugiperda).

Modo de ação Monterey










Benefícios do produto
Ideal para Manejo Integrado de Pragas (MIP).

Indicado para manejo de resistência de insetos-praga a inseticidas químicos.


Após aplicação de MONTEREY na cultura, uma nuvem de feromônios é liberada, causando a confusão sexual nas mariposas de S. frugiperda machos, dificultando o encontro dos machos com as fêmeas e, consequentemente, evitando o processo de acasalamento. Isso pode levar a uma redução na postura de ovos impactando diretamente e negativamente no aumento populacional.






Não possui período de carência.













Vírus HearNPV / Vírus ChinNPV
DIPLOMATA EVO é um bioinseticida com eficiência agronômica comprovada no controle de Chrysodeixis includens (Lagarta-falsa-medideira) e Helicoverpa armigera.











Linhagem:
Baculovírus Helicoverpa armigera
Baculovírus Chrysodeixis includens

CEPA: Todas as culturas

Registro no MAPA: 7923




Alvos




Chrysodeixis includens (Lagarta-falsa-medideira) e Helicoverpa armigera.

de ação Diplomata Evo




As partículas virais são pulverizadas e recobrem a planta.



A lagarta se alimenta da planta e ingere as partículas virais.
A lagarta infectada para de se alimentar e sua coloração evolui para esbranquiçado.










Benefícios do produto


Ideal para Manejo Integrado de Pragas (MIP).
Não possui período de carência.
Após a morte a lagarta se liquefaz, espalhando um líquido contendo o vírus na superfície da planta.


Preserva os inimigos naturais das pragas.



A lagarta morta espalha partículas do vírus que irão infectar outras lagartas.
Indicado para manejo de resistência de insetos-praga a inseticidas químicos.
*Informações sobre dosagem e modo de aplicação, consultar a bula do produto disponível no QRCode ao lado.











TRIANUM DS é um biofungicida e bionematicida indicado para Tratamento de Semente Industrial (TSI) com eficiência agronômica comprovada no controle de fungos e nematoides de solo. Trichoderma harzianum T22












T22

Indicação: Todas as culturas

Registro no MAPA: 27618







Nematoide-das-lesões (Pratylenchus brachyurus), Podridão-cinzenta-do-caule (Macrophomina phaseolina), Murcha-de-fusarium (Fusarium oxysporum f.sp. lycopersici) e Mofo-branco (Sclerotinia sclerotiorum).






















Micoparasitismo: 1
Trichoderma é capaz de parasitar fungos fitopatogênicos.
Benefícios do produto






2
Competição:
Trichoderma coloniza o sistema radicular da planta competindo com fitopatógenos por espaço e alimento.








Redução do inóculo de doenças de solo (fungos e nematoides).
Maior atividade na rizosfera da planta.




3
Antibiose:
Trichoderma secreta diversos metabólitos secundários que são capazes de inibir e proteger as raízes contra a ação de fungos e nematoides fitopatogênicos.







Tecnologia BIOTSI (tratamento biológico de semente industrial). 29
*Informações sobre dosagem e modo de aplicação, consultar a bula do produto disponível no QRCode ao lado.






VERANEIO é um bionematicida com eficiência agronômica comprovada no controle de nematoides. Com seu biofilme formado ao redor da raiz, promove a proteção da planta desde a sua fase inicial.











CEPA: UMAF6614 (Universidade de Málaga)

Indicação: Todas as culturas

Registro no MAPA: 11620








Nematoide-das-galhas (Meloidogyne incognita, Meloidogyne javanica) e Nematoide-das-lesões (Pratylenchus brachyurus).

Modo de ação Veraneio





Benefícios do produto Alvos








A bactéria produz metabólitos e forma um biofilme protetor nas raízes, inibindo a ação de patógenos e fitonematoides.






Redução do inóculo de doenças de solo (nematoides).

Maior atividade na rizosfera da planta.


Bacillus amyloliquefaciens






Tecnologia BIOTSI (Tratamento Biológico de Semente Industrial). 31
*Informações sobre dosagem e modo de aplicação, consultar a bula do produto disponível no QRCode ao lado.




Os agentes macrobiológicos da Koppert para controle de pragas também são uma importante ferramenta de manejo biológico. Os produtos da linha Bug são compostos de microvespas que parasitam os ovos dos insetos invasores, controlando sua população, e nematoides benéficos, mantendo a sanidade das lavouras.














Trichogramma pretiosum
PRETIOBUG é uma microvespa parasitoide com eficiência agronômica comprovada no controle de Lepidópteros.











Liberação: Via drone by NATUTEC*

Indicação: Todas as culturas

Registro no MAPA: 2315
*Vendidos separadamente. Consulte condições comerciais.




Alvos




Lagarta-da-soja (Anticarsia gemmatalis), Lagarta-militar (Spodoptera frugiperda),
Broca-grande-do-fruto (Helicoverpa zea) e Lagarta-falsa-medideira (Chrysodeixis includens)

Modo de ação Pretiobug





Trichogramma localiza e parasita ovos das pragas. 1


A vespa emerge do ovo da lagarta e busca por ovos das pragas. 3

Benefícios do produto

O Trichogramma se desenvolve dentro do ovo do hospedeiro.

O escurecimento dos ovos indica o parasitismo. 2


Indicado para manejo de resistência de insetos-praga a inseticidas químicos.


Preserva os inimigos naturais das pragas. Ideal para Manejo Integrado de Pragas (MIP).









A marca global de drones da Koppert oferece ao mercado brasileiro tecnologia e inovação na aplicação de agentes biológicos de forma precisa, eficaz e rentável. Trata-se de uma solução completa que garante o desempenho máximo dos biodefensivos no campo.
A tecnologia Natutec de liberação via drones distribui os ovos a granel de um hospedeiro alternativo, parasitado pela vespa Trichogramma, diretamente na cultura afetada, por meio de um dispenser rotativo preciso.


Garante a distribuição homogênea e georreferenciada do agente e a entrega de mapas de pós-liberação. No caso do Trichogramma, a cobertura média chega a 350 ha/dia/drone.
O manejo integrado da broca-da-cana utiliza o método biológico, principalmente, com a vespa parasitoide Cotesia flavipes, que se alimenta da praga. Na liberação com os drones, as vespas são colocadas em recipientes desenvolvidos com celulose biodegradável, que além de não causarem impacto ao meio ambiente, oferecem conforto térmico e segurança para o agente biológico.
Outro fator importante é o tempo muito inferior de cobertura de hectares por dia, se comparado ao método tradicional, de 250 ha/dia/drone em média.


Pulverização de microbiológicos
A pulverização de defensivos microbiológicos é um grande aliado no manejo.
A operação é programada por dados georreferenciados, garantindo aplicação exata do defensivo sobre a área afetada, através dos sensores precisos e controle do dosador, altura e velocidade ideais, evitando desperdício de produto.

Além dos serviços de pulverização e liberação de defensivos biológicos, a Natutec oferece soluções de imageamento aéreo das lavouras para suportar a tomada de decisão dos gestores das propriedades rurais. Entre elas estão: matocompetição; identificação de falhas de plantio; planialtimetria; geração de linhas de colheita, ortomosaico; modelo digital de superfície do terreno; fluxo hídrico; e contagem de plantas.


Um monitoramento eficiente de pragas é a chave para o sucesso do controle biológico e do MIP (Manejo Integrado de Pragas). Somente quando o agricultor conhece o nível de infestação, a tomada de decisão é eficiente. Para o registro dessas informações, a Koppert tem armadilhas e ferramentas de acompanhamento.


Dispositivo que conta com sensores de umidade do solo, que fazem as medições e o acompanhamento das condições de clima e solo na área monitorada.
Com essa ferramenta, o agricultor pode planejar melhor as atividades de campo como plantio, aplicação de insumos e colheita.


Horiver é uma armadilha adesiva com ilustrações de grades que auxilia na contagem dos insetos e na verificação do nível de infestação.



Portfólio


Os inoculantes são insumos biológicos capazes de desempenhar atividades benéficas e necessárias para o desenvolvimento das plantas. Eles contêm bactérias que intensificam o processo natural de fixação biológica de nitrogênio, otimizando o potencial das plantas e a resiliência dos cultivos.
Já os bioativadores são produtos formulados com o extrato da alga marinha Ascophyllum nodosum, que promovem o crescimento das plantas e melhoram sua resistência frente aos estresses e ao ataque de pragas e doenças. Assim, promovem maior crescimento radicular e vegetativo e consequente incremento de produtividade.












Azospirillum brasilense
AZOKOP é um inoculante que promove a Fixação Biológica de Nitrogênio (FBN) e auxilia na promoção de crescimento e resistência das plantas.















Objetivos



• Maior desenvolvimento de plantas.
• Melhora a eficiência de uso de fertilizantes.
• Melhora a resistência ao estresse hídrico.

Modo de ação Azokop










Azospirillum promove o crescimento das plantas, realiza a fixação biológica de nitrogênio e a síntese de hormônios que promove maior produtividade.














Benefícios do produto
Maior desenvolvimento radicular.
Melhor aproveitamento dos nutrientes disponíveis no solo.








Estratégia para aumento de produtividade da cultura.












Bradyrhizobium japonicum
RIZOKOP, RIZOKOP PLUS e RIZOKOP TSI são inoculantes para Tratamento de Semente Industrial que promovem a Fixação Biológica de Nitrogênio (FBN) e auxiliam na promoção de crescimento e resistência das plantas.













• Contribuem diretamente na Fixação Biológica de Nitrogênio (FBN).


• Melhoram a resistência ao estresse hídrico.
• Estratégia para aumento de produtividade da cultura.


O nitrogênio da atmosfera é captado pelas bactérias que colonizaram as raízes das plantas.


























O nitrogênio atmosférico metabolizado pelos rizóbios sofre amonificação (NH4+) e nitrificação (NO3-) e assim consegue ser assimilado e utilizado pelas plantas.
3
As bactérias fixadoras de nitrogênio (rizóbios) invadem as raízes, se multiplicam e formam nódulos radiculares, vivendo em simbiose.
RIZOKOP: Produto indicado para plantio imediato logo após a inoculação das sementes.
RIZOKOP PLUS: Proporciona longevidade e viabilidade de até 07 dias após o tratamento das sementes.
Melhoram a nodulação e eficiência da FBN em soja.


Melhoram a eficiência de uso de fertilizantes.


RIZOKOP TSI: Possibilita o armazenamento das sementes em até 30 dias após o tratamento.

Tecnologia BIOTSI (Tratamento Biológico de Semente Industrial).









Ascophyllum nodosum
STINGRAY é um bioativador 100% natural para todas as fases do seu cultivo que contribui para maior equilíbrio hormonal e nutricional.











Espécie: 100% Ascophyllum nodosum

Indicação: Todas as culturas

Registro no MAPA: SP 002821-5000004




Objetivos



• Tolerância a estresses biótico e abiótico.
• Maior produtividade e melhor qualidade da produção final.
• Aumento de rendimentos.

Modo de ação Stingray
Ascophyllum nodosum estimula maior vigor no desenvolvimento das plantas e de seus frutos, devido aos compostos bioativadores. As plantas toleram o estresse abiótico e sua capacidade genética para produção é ativada.


























































Trata-se de uma nova linha de produtos desenvolvida para potencializar a ação de insumos biológicos no campo. Os adjuvantes reduzem a tensão superficial e aumentam a superfície de contato da gota com a folha e inseto, promovendo maior espalhamento e cobertura na área aplicada. Dessa forma, proporcionam maior uniformidade no tamanho das gotas, controle na pulverização e atingimento do alvo, evitando danos econômicos.


Além disso, é um produto biodegradável e biocompatível com os produtos Koppert (fungos, vírus, nematoides entomopatogênicos NEPs e bactérias).















RANCHERO é um adjuvante desenvolvido para potencializar a aplicação de produtos biológicos no campo. Possui ação espessante de calda, que melhora o espectro das gotas pulverizadas, e reduz perdas por deriva. Com ação super espalhante e adesivante, RANCHERO é recomendado para aplicações agrícolas que demandam o máximo aproveitamento e eficiência.
Apresenta compatibilidade e sinergia com todos os produtos do Portfólio Koppert.









Indicação: Todas as culturas





Características




• Tipo de formulação: (EC) Concentrado Emulsionável.


• Otimiza a aplicação, favorecendo a ação de produtos biológicos no campo.
• Recomendado para aplicações agrícolas que demandam o máximo aproveitamento e eficiência.

Modo de ação Ranchero
Ranchero é pulverizado em mistura de calda com produtos fitossanitários: biológicos ou químicos.







Ranchero melhora o espectro de gotas pulverizadas, aumenta o DMV - Diâmetro Médio Volumétrico, e reduz perdas por deriva.

• Possui ação espessante de calda, que melhora o espectro das gotas pulverizadas, e reduz perdas por deriva.








Ranchero é compatível e favorece a aplicação de produtos biológicos na calda de pulverização.
Não interfere na germinação dos microrganismos, bioinseticidas, biofungicidas e nematicidas.





Benefícios do produto

Produto biodegradável. Não deixa resíduos na lavoura.


Sinergia com produtos biológicos, favorece ação de fungos, bactérias e vírus de biocontrole.






Com ação super espalhante e adesivante, Ranchero reduz o ângulo de contato das gotas sobre a superfície foliar e tegumento do inseto, promovendo redução da tensão superficial da calda.


Proporciona maior uniformidade no tamanho das gotas, controle na pulverização e atingimento do alvo.












Intervalo 7 dias




Intervalo
Tecnologia de aplicação via sulco by:

Aplicações com intervalo de 7 a 10 dias entre as aplicações 1ª aplicação no estágio V3




Intervalo 7 dias












5 aplicações com intervalo de 7 a 10 dias entre as aplicações 1ª aplicação no estágio VE / V1




Tecnologia de aplicação via sulco by:



Intervalo de 15 dias entre as aplicações

Liberação via drone
Intervalo 7 dias











Liberação via drone
Intervalo 7 dias
10 aplicações com Intervalo de 7 a 10 dias entre
Intervalo de 10 dias entre as aplicações
Liberação via drone
Intervalo 7 dias





Tecnologia de aplicação via sulco by:



as aplicações 1ª aplicação no estágio B1











os direitos reservados
ilustrativas.

Acesse nossas plataformas digitais.




koppert.com.br


PROTEÇÃO À SAÚDE HUMANA, ANIMAL E AO MEIO AMBIENTE. ATENÇÃO: USO EXCLUSIVAMENTE AGRÍCOLA. VENDA SOB RECEITUÁRIO AGRONÔMICO QUANDO EXIGIDO POR LEGISLAÇÃO. CONSULTE SEMPRE UM ENGENHEIRO AGRÔNOMO. SIGA RIGOROSAMENTE AS INSTRUÇÕES CONTIDAS NO RÓTULO, NA BULA E NA RECEITA. UTILIZE SEMPRE OS EQUIPAMENTOS DE PROTEÇÃO INDIVIDUAL. NUNCA PERMITA A UTILIZAÇÃO DO PRODUTO POR MENORES DE IDADE. FAÇA O MANEJO INTEGRADO DE PRAGAS. PERICULOSIDADE AMBIENTAL E DEMAIS INFORMAÇÕES VIDE RÓTULO, BULA E RECEITA. EVITE CONTAMINAÇÃO AMBIENTAL, PRESERVE A NATUREZA. DESCARTE CORRETAMENTE AS EMBALAGENS E RESTOS DE PRODUTOS.
EXCLUSIVO PARA AGRICULTORES E PROFISSIONAIS DO AGRO.
Atualização: Outubro/2024

